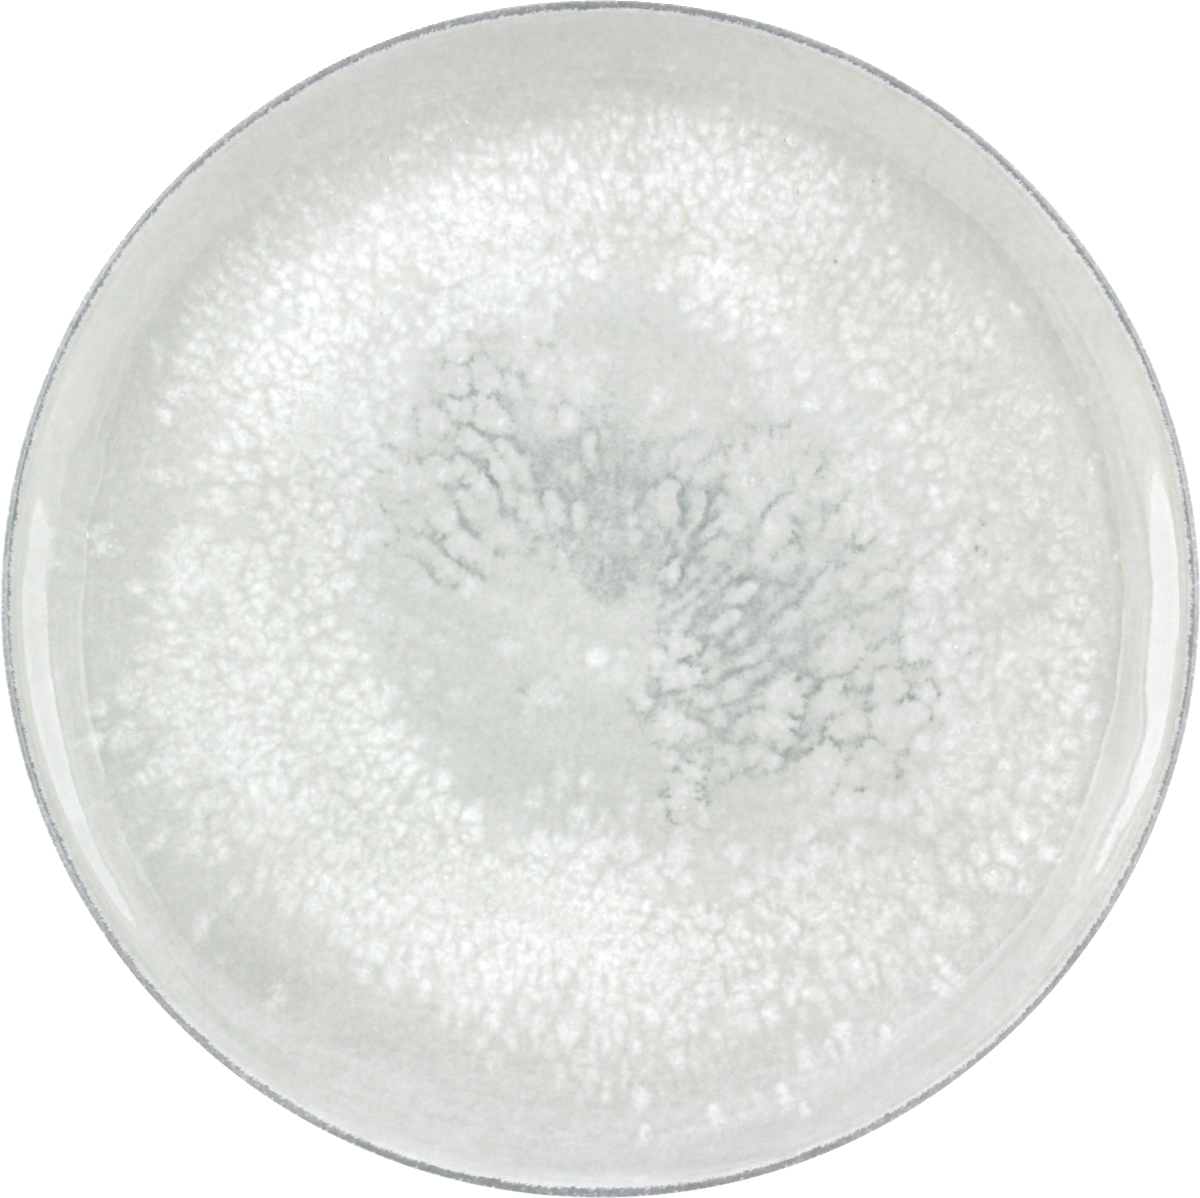

1
/
av
1
BAUSCHER
Plate flat round coupe 26cm SALT
Plate flat round coupe 26cm SALT
Lagerhållningsenhet:675122711425943
Series:
SMART
Material:
Porcelain
Produktkategori:
Flata tallrikar
Diameter: 261mm
Höjd: 20mm
Vikt: 685g
SMART-serien från BHS
Fokuserar på det väsentliga. Serien erbjuder mångsidighet och en modern design med ett fåtal genomtänkta delar. Perfekt för den medvetna kunden som söker tyskt hårdporslin av hög kvalitet till attraktiva priser.
SMART-kollektionen från Bauscher är intelligent utformad för att lyfta fram moderna maträtter och drycker. Den finns i tidlöst vitt porslin samt med trendiga dekorer och coup-design, alltid i professionell kvalitet och ”Made in Germany”.
Dela